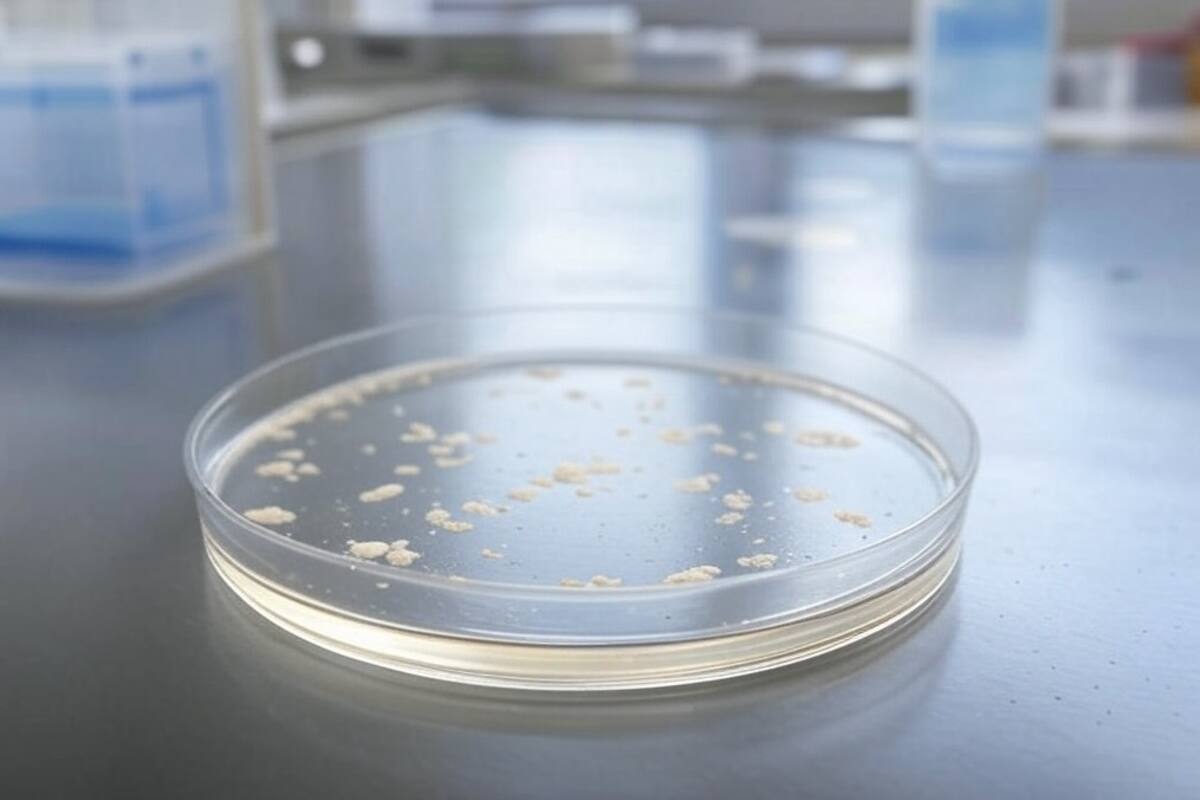
Alerta sanitaria: hongo mortal se propaga rápidamente en hospitales de EU, ¿Llegará a México?

Alerta sanitaria: hongo mortal se propaga rápidamente en hospitales de EU, ¿Llegará a México?
Se han detectado nuevos casos de un hongo peligroso y resistente a los tratamientos en al menos dos hospitales estatales de EU.
Se han detectado nuevos casos de un hongo peligroso y resistente a los tratamientos en al menos dos hospitales estatales de Estados Unidos.
Candida auris, conocida también como C. auris, fue identificada por primera vez en Estados Unidos en 2016. Desde entonces, los casos han ido en aumento cada año, con un notable incremento en 2023, según los últimos datos disponibles de los Centros para el Control y la Prevención de Enfermedades (CDC).
Durant3e ese año se reportaron 4 mil 514 nuevos casos clínicos de C. auris.
Recientemente, Georgia ha registrado un aumento en los casos, de acuerdo con el informe del Departamento de Salud estatal citado por WJCL. Un estudio publicado esta semana, que se centra en el Sistema de Salud Jackson de Miami, también ha revelado un aumento acelerado en los casos de esta infección.
Los CDC han señalado a Candida auris como una amenaza urgente por su resistencia a los antimicrobianos, ya que es resistente a los medicamentos antimicóticos, lo que complica su tratamiento una vez que se ha contraído la infección.
“Si una persona se infecta con este hongo resistente a los tratamientos, no hay nada que podamos hacer para combatirlo. Está a la deriva”, explicó Melissa Nolan, profesora adjunta de epidemiología y bioestadística en la Universidad de Carolina del Sur, en entrevista con Nexstar.
Aunque las personas con un sistema inmunológico saludable pueden luchar contra la infección por sí solas, Candida auris se transmite principalmente en ambientes hospitalarios, donde los pacientes son más vulnerables. Aquellos que tienen catéteres, tubos respiratorios, de alimentación o catéteres PICC están más expuestos, ya que el hongo puede entrar al cuerpo a través de estos dispositivos.
Identificar la causa de la infección puede ser complicado, pues los síntomas de Candida auris son similares a los de cualquier otra infección, como fiebre y escalofríos.
Otro factor que hace que Candida auris sea tan preocupante es su capacidad para sobrevivir en superficies como encimeras, barandillas de cama y pomos de puertas.
“Este hongo se adapta perfectamente a su entorno”, señaló Nolan. “Si está presente, por ejemplo, en la barandilla de la cama de un paciente, y se realiza una limpieza general, pero no se eliminan todos los patógenos, estos pueden volverse más resistentes y proliferar con el tiempo en el ambiente hospitalario”.
No solo los hospitales en Georgia y Florida están en alerta. Candida auris ha sido detectada en todos los estados, excepto en 12, con un aumento notable entre 2022 y 2023, indica The Hill.
Los CDC estimaron previamente que entre el 30% y el 60% de los pacientes con infecciones por C. auris han fallecido, aunque muchos de estos pacientes también padecían otras enfermedades graves que incrementaban su riesgo de muerte.
| Ubicación | Casos clínicos de C. auris |
|---|---|
| Alaska | 0 |
| Alabama | 19 |
| Arkansas | 10 |
| Arizona | 179 |
| California | 1,566 |
| Colorado | 3 |
| Connecticut | 8 |
| District Of Columbia | 97 |
| Delaware | 30 |
| Florida | 1,485 |
| Georgia | 219 |
| Hawaii | 1 |
| Iowa | 6 |
| Idaho | 0 |
| Illinois | 1,627 |
| Indiana | 304 |
| Kansas | 0 |
| Kentucky | 48 |
| Louisiana | 38 |
| Massachusetts | 23 |
| Maryland | 203 |
| Maine | 0 |
| Michigan | 149 |
| Minnesota | 8 |
| Missouri | 4 |
| Mississippi | 41 |
| Montana | 0 |
| North Carolina | 20 |
| North Dakota | 0 |
| Nebraska | 2 |
| New Hampshire | 0 |
| New Jersey | 491 |
| New Mexico | 1 |
| Nevada | 1,008 |
| New York | 1,795 |
| Ohio | 274 |
| Oklahoma | 10 |
| Oregon | 4 |
| Pennsylvania | 44 |
| Rhode Island | 0 |
| South Carolina | 8 |
| South Dakota | 0 |
| Tennessee | 107 |
| Texas | 750 |
| Utah | 1 |
| Virginia | 151 |
| Vermont | 0 |
| Washington | 0 |
| Wisconsin | 12 |
| West Virginia | 4 |
| Wyoming | 0 |
Casos de C. auris por estadoe, 2016-2023 (Información: CDC)
Casos en México
La información más reciente sobre los casos de Candida auris en México proviene de un estudio publicado en diciembre de 2024.
Este estudio describe un brote multicéntrico en instituciones privadas de Monterrey, Nuevo León, donde se identificaron 37 casos entre septiembre de 2020 y diciembre de 2023.
Anteriormente, en agosto de 2021, la Secretaría de Salud reportó 40 casos confirmados en cinco hospitales de Nuevo León y un caso en Tabasco.
Sigue nuestro canal de WhatsApp
Recibe las noticias más importantes del día. Da click aquí
Te recomendamos

Brote de enfermedad hemorrágica epizoótica alerta a cazadores en Estados Unidos

Alejandro Aguilar, el joven mexicano ganador de premio James Dyson Award por una App que detecta enfermedades en la retina

Cuidado con consultarse en ChatGPT

Longevidad femenina: qué dicen los expertos sobre salud, ejercicio y envejecimiento

Grupo Healy © Copyright Impresora y Editorial S.A. de C.V. Todos los derechos reservados